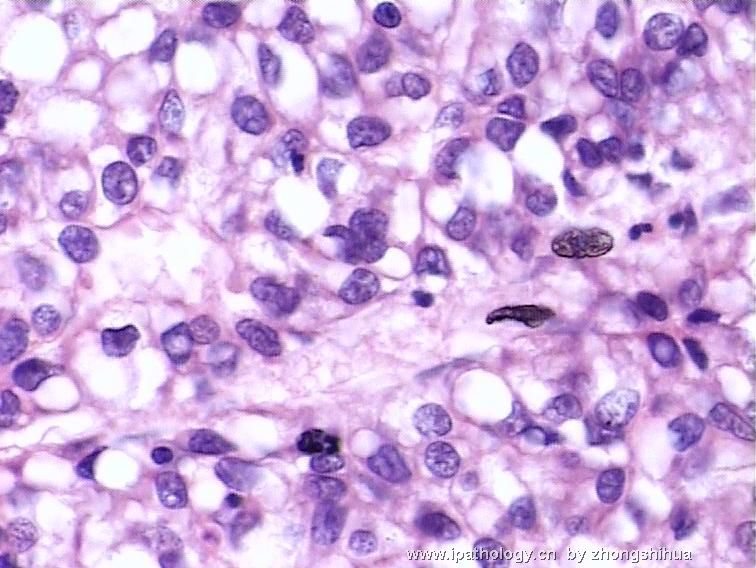

小细胞癌补硒有用不(补硒治疗癌症)
我有个朋友叫小邓,说起他的病情啊,那可真是让人揪心呢!
一开始,小邓总觉得自己浑身没劲儿,还经常头痛头晕。起初以为只是工作太累,休息一下就好了,没想到症状越来越严重。后来实在受不了了,他就去了医院检查,结果发现自己的肝功能出了问题,进一步检查后确诊为肝癌。可以进行补硒,硒对肝癌的作用主要体现在抗氧化、调节免疫、保护肝脏、抗肝纤维化、辅助治疗肝癌等方面。
听到这个消息,小邓整个人都崩溃了。但是,他并没有放弃希望,而是积极地配合医生治疗。听取医生的建议,小邓开始补充硒元素,每天吃上一片含硒保健品。就这样,经过四年的坚持,他的病情得到了有效的控制,最终完全康复了。

现在的小邓已经恢复了健康,重新回归到正常生活中。虽然曾经经历过疾病的折磨,但他依然保持着乐观的心态,坚信只要有信心,就一定能战胜任何困难。

你可能不知道,补硒对于癌症患者的康复有多重要!小邓的经历告诉我们,面对疾病时保持信心和勇气是关键。接下来,让我们来看看小邓是如何通过补硒、肝功能保护和戒烟来战胜肝癌的吧!

✅补硒:小邓听从医生的建议,每天服用一片含硒保健品。硒是一种重要的微量元素,能够增强免疫力,抑制肿瘤细胞的增长。小邓一直坚持服用,没有间断过。

肝功能保护:由于小邓被诊断出患有肝癌,所以他在日常饮食中特别注意保护肝脏。他避免饮酒,并且尽量减少摄入高脂肪、高糖分的食物。此外,他还定期进行体检,监测肝功能指标的变化。
.戒烟: 小邓意识到吸烟会加重肝脏负担,因此果断戒掉了烟瘾。他知道吸烟不仅对肝脏有害,还会增加患其他疾病的风险。戒烟的过程并不容易,但小邓坚定信念,最终成功摆脱了烟草依赖。
面对疾病,我们可能会感到无助和恐惧。然而,像小邓这样的例子告诉我们,只要我们采取正确的措施,相信自己,就一定能够战胜疾病。希望这些小技巧能帮助大家更好地保护身体健康,也欢迎大家在评论区分享自己的经验和故事。
继续阅读
- 暂无推荐
